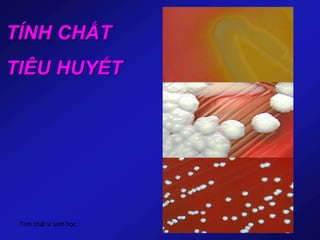
Tính chất vi sinh học
TÍNH CHẤT
TIÊU HUYẾT
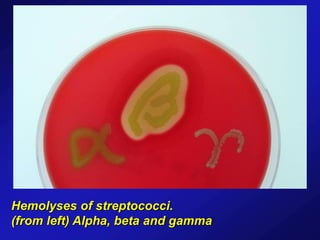
Hemolyses of streptococci.
(from left) Alpha, beta and gamma
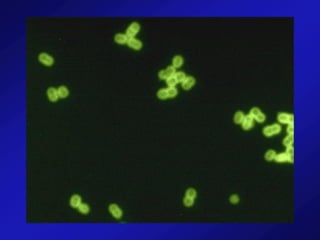

Tài liệu cung cấp cái nhìn tổng quan về các vi khuẩn gây bệnh như staphylococci, streptococci, neisseria gonorrhoeae và neisseria meningitidis, bao gồm đặc điểm sinh học, cơ chế gây bệnh và các phương pháp chẩn đoán. Các vi khuẩn này có thể gây ra nhiều bệnh lý cấp tính và mãn tính, cũng như có khả năng kháng thuốc gia tăng. Điều trị thường dựa vào kháng sinh và các biện pháp y tế khẩn cấp.